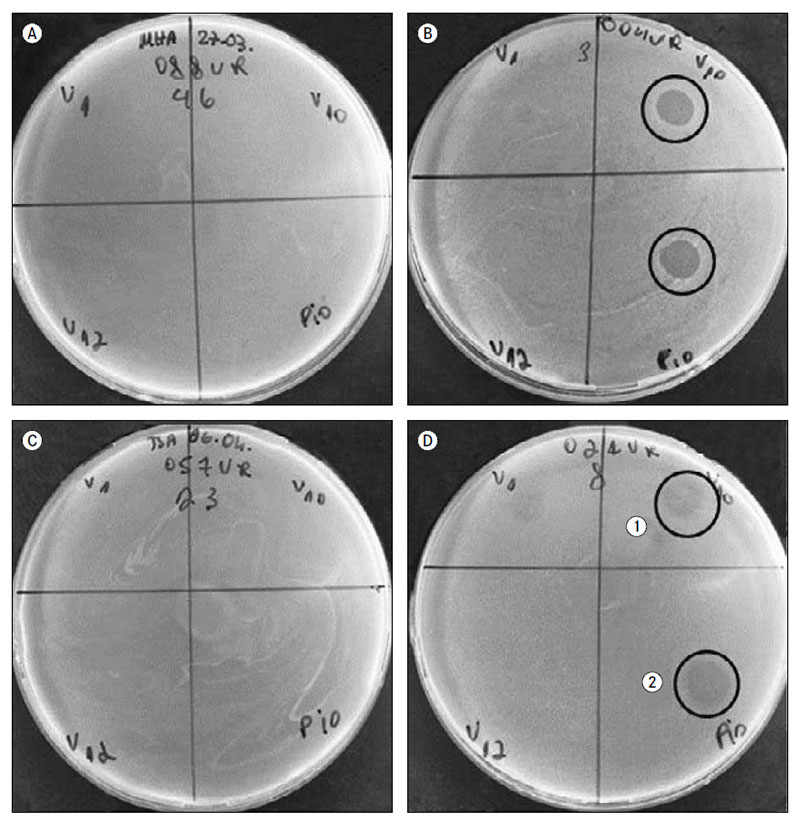

Bakteriofāgu lītiskā efekta vērtējums biofilmu producējošās uropatogēnās E. coli kultūrās
Kopsavilkums
Pēdējo gadu laikā multirezistento mikroorganismu ierosināto infekciju skaits ir pieaudzis. Aptuveni 85 % gadījumu urīnceļu infekcijas (UCI) ierosinātājs ir E. coli, un to bieži saista ar baktērijas spēju veidot biofilmu. Biofilmas ir baktēriju aizsargmehānisms pret cilvēka imūnsistēmu, kā arī pret antibakteriālajiem līdzekļiem, kuri vāji penetrē biofilmu. Alternatīva metode antibakteriālu vielu lietošanai ir bakteriofāgu jeb baktēriju vīrusu izmantošana. Ir novērots, ka bakteriofāgiem ir arī spēcīgs lītiskais efekts baktēriju biofilmās.
Darba mērķis – novērtēt uropatogēno E. coli celmu spēju veidot biofilmu in vitro apstākļos, izvērtēt bakteriofāgu antimikrobiālo efektu izolētajās kultūrās.
Eksperimentālā in vitro pētījumā izmantotas no UCI slimniekiem izdalītas 45 E. coli kultūras un trīs E. coli references celmi (ATCC – 33526 un 35218, 25922). Baktēriju spēja veidot biofilmu tika noteikta, izmantojot 96 bedrīšu mikroplati. Rezultāta izvērtēšanai tika mērīts krāsoto biofilmu optiskais blīvums. Biofilmas producēšana tika vērtēta, ņemot vērā vidējo aprēķināto optisko blīvumu, un tika izteikta biofilmas veidošanās pakāpe. Tika izmantots E. coli bakteriofāgu maisījums “Piofag” (Mikrogen) un trīs lītiski E. coli bakteriofāgi.
Izvērtējot biofilmas producēšanu, novērots, ka viena (2 %) kultūra biofilmu neveido, 23 (51 %) veido vāji, 12 (27 %) – vidēji, bet 9 (20 %) – izteikti. Nozīmīga, t. i., vidēja vai izteikta, biofilmas veidošana novērota 21 (47 %) kultūrā. Izvērtējot bakteriofāgu lītisko efektu atkarībā no baktēriju spējas veidot biofilmu, noteikts, ka celmos ar nozīmīgu biofilmas veidošanu bakteriofāgu lītiskais efekts vērojams 18 (86 %) kultūrās no 21 kultūras.
Secinājumi: klīniskajiem celmiem biofilma veidojas bieži; bakteriofāgiem piemīt salīdzinoši plašs lītiskais efekts biofilmu producējošās kultūrās, tajā skaitā arī paplašināta spektra beta-laktamāzes (extended-spectrum beta-lactamases – ESBL) producējošās E. coli kultūrās; bakteriofāgiem ir vērojams potenciāls biofilmu producējošu baktēriju celmu iznīcināšanā.
Ievads
Multirezistento mikroorganismu infekciju biežums pasaulē arvien pieaug, savukārt efektīvu antimikrobiālo līdzekļu kļūst arvien mazāk. Eiropas Savienības komisija 2011. gadā ziņoja, ka ik gadu 25 tūkstoši cilvēku mirst bakteriālās rezistences dēļ, un tiek prognozēts, ka šis skaits turpinās pieaugt (European Commission, 2016; Melzer and Petersen, 2007). Viena no biežākajām intrahospitālajām un sadzīvē iegūtajām infekcijām ir urīnceļu infekcija (UCI) – aptuveni 30 % no nozokomiālām infekcijām (Lacovelli et al., 2014). Aptuveni 85 % gadījumu UCI ierosinātājs ir E. coli, turklāt pa- plašināta spektra beta laktamāzes (extended-spectrum beta-lactamases – ESBL) producējošas E. coli infekcijas gadījumā mirstības risks pieaug 3,57 reizes (European Commission, 2016; Melzer and Petersen, 2007).
E. coli ierosināta UCI bieži tiek saistīta ar baktērijas spēju veidot biofilmu jeb ekstracelulāru matriksu, un īpaši augsts risks ir pacientiem ar urīnceļu katetru. Biofilmas veidošana ir baktēriju aizsargmehānisms pret cilvēka imūnsistēmu, kā arī pret antibakteriālajiem līdzekļiem, kuri vāji penetrē biofilmu, padarot baktērijas grūti iznīcināmas (Jacobsen et al., 2008). Lielākā daļa E. coli celmu spēj veidot dažādas pakāpes biofilmas, tomēr par klīniski nozīmīgu tiek uzskatīta vidēja un izteikta biofilmas veidošana (Hassan et al., 2011).
Multirezistentu mikroorganismu ierosinātu, īpaši ar biofilmu veidošanu asociētu, infekciju dēļ pieaug mirstība, invaliditātes risks un ārstēšanas izmaksas, tādēļ Eiropas Savienībā ir izveidots rīcības plāns bakteriālās rezistences apkarošanai un ierobežošanai. Tas ietver jaunu antimikrobiālo līdzekļu izveidošanu un alternatīvu metožu attīstīšanu (European Commission, 2016; Centers for Disease Control and Prevention, 2013). Viena no šādām metodēm ir bakteriofāgu jeb baktēriju vīrusu izmantošana infekciju profilaksē un ārstēšanā (European Commission, 2015; Review on Antibacterial Resistance, 2016).
Darba mērķis
Novērtēt uropatogēno E. coli celmu spēju veidot biofilmu in vitro apstākļos, izvērtēt bakteriofāgu antimikrobiālo efektu izolētajās, t. sk. ESBL producējošās E. coli un biofilmu veidojošās, kultūrās.
Materiāls un metodes
Tika veikts eksperimentāls in vitro pētījums. Darbā izmantotas 45 E. coli kultūras, kuras izdalītas no urīna paraugiem pacientiem ar urīnceļu infekciju, kuri bija stacionēti Paula Stradiņa Klīniskās universitātes slimnīcas Nefroloģijas centrā (30 kultūras) un Uroloģijas nodaļā (15 kultūras), kā arī trīs komerciāli pieejami E. coli references celmi (ATCC – 33526 un 35218, 25922).
Urīna paraugi izmeklēti, izmantojot mikrobioloģijas standartmetodes, darbā iekļautas kultūras ar titru > 105 koloniju veidojošās vienības mililitrā (KVV/ml). Baktēriju identifikācijai izmantota VITEK-2 (bioMerieux) sistēma. Mikroorganismu antibakteriālā jutība tika noteikta ar disku difūzijas metodi (EUCAST 4.0).
Baktēriju spēja veidot biofilmu tika noteikta, izmantojot 96 bedrīšu mikroplati. Sākotnēji tika izdalīta baktēriju tīrkultūra pēc Golda metodes uz triptikāzes sojas agara, tad 24 stundas veikta celma kultivēšana Luria-Bertani (LB) šķidrā barotnē 37 °C. Pēc kultivēšanas izveidota baktēriju suspensija LB barotnē ar atšķaidījumu 1 : 100.
Izmantojot multikanālu pipeti, kultūras tika pārnestas 96 bedrīšu platē, katrā bedrītē ievietojot 200 μl iepriekš pagatavotās suspensijas. Vienai E. coli kultūrai izmantotas 32 bedrītes. Trīs atsevišķās mikroplatēs ar 32 bedrītēm katrā (kopā 96 bedrītēs) tika ievietota negatīvā kontrole – sterila LB barotne. Biofilmu produkcijai mikroplates inkubētas 20 ± 1 h 37 °C.
Pēc inkubācijas perioda mikroplatēs saaugušās planktoniskās šūnas tika nolietas, tad mikroplašu bedrītes divas reizes skalotas ar multikanālu pipeti ar 200 μl fizioloģiskā šķīduma. Pēc skalošanas 20 minūtes veikta biofilmas krāsošana, katru bedrīti uzpildot ar 200 μl 0,1 % kristālvioletā šķīduma. Tad tika atkārtota mikroplašu skalošana, katru bedrīti trīs reizes uzpildot ar 200 μl destilēta ūdens. Kā biofilmu atkrāsotājs izmantots 96 % etanola šķīdums, kurš tika uzpildīts (200 μl) un samaisīts ar multikanālu pipeti.
Rezultāta izvērtēšanai tika mērīts krāsoto biofilmu optiskais blīvums, izmantojot optiskā blīvuma mērītāju TECAN INFINITE F50 (viļņa garums – 620 nm). Biofilmas producēšana vērtēta dažādās pakāpēs, salīdzinot ar negatīvo kontroli. Rezultāts tika izvērtēts kā biofilmu neproducējošs, vāji, vidēji, izteikti producējošs E. coli celms, ņemot vērā aprēķināto vidējo optisko blīvumu (sk. 1. tab.) (Stepanovic et al., 2007; Reisner et al., 2006; Rodrigues et al., 2010).
1. tabula. Biofilmas optiskā blīvuma interpretācija*
Interpretation of biofilm optical density
| Vidējā kultūras OD vērtība | Biofilmas veidošanās pakāpe |
|---|---|
| ODs ≤ ODc | Nenovēro |
| ODc < ODs ≤ 2 × ODc | Vāja |
| 2 × ODc < ODs ≤ 4 × ODc | Vidēja |
| 4 × ODc < ODs | Izteikta |
* Par celmu ar nozīmīgu biofilmas veidošanu tiek uzskatīts tāds celms, kurš biofilmu producē vidēji vai izteikti.
OD – optiskais blīvums; ODs – katra celma 32 mērījumu vidējais optiskais blīvums;
ODc – optiskā blīvuma robežvērtība, kuru aprēķina kā 96 mērījumu negatīvās kontroles vidējo vērtību + 3 standartnovirzes no negatīvās kontroles.
Darbā tika izmantots E. coli bakteriofāgu maisījums “Piofag” (Mikrogen) un no “Sekstofag” (Mikrogen) izdalīti E. coli Myoviridae dzimtas T4 grupas bakteriofāgi V10, V12, kā arī E. coli Siphoviridae dzimtas bakteriofāgs V1. Bakteriofāgu lītiskais efekts noteikts, izmantojot divslāņu agara punkta metodi, vērtējot lītiskās zonas esamību. Kā pozitīvs rezultāts bija pilna baktēriju lizēšana, daļēja baktēriju līze un atsevišķu negatīvo koloniju veidošanās. Par negatīvu rezultātu tika uzskatīta līzes zonas neesamība jeb celma rezistence pret fāgu (sk. 1. att.). Iegūtie dati analizēti, izmantojot Microsoft Excel un IBM SPSS Statistics datorprogrammu.
Rezultāti
Tika izmantoti 3 references celmi un 45 E. coli kultūras, kuras izdalītas no urīna paraugiem pacientiem ar urīnceļu infekciju (UCI), kuri bija stacionēti Paula Stradiņa Klīniskās universitātes slimnīcas Nefroloģijas centrā (30 kultūras) un Uroloģijas nodaļā (15 kultūras).
Veicot baktēriju mikrobioloģisko testēšanu ar VITEK-2 sistēmu, identifikācijas precizitāte variēja no 93 % līdz 99 %. No 45 izolētajām E. coli kultūrām pret flurokvinoloniem rezistentas bija 14 (31 %), gentamicīnu – 4 (9 %), kotrimoksazolu – 13 (29 %), piperacilīnu / tazobaktāmu – 5 (11 %) kultūras. Astoņas (18 %) kultūras bija ESBL producējošas, tām visām tika novērota korezistence pret flurokvinolonu grupas antibakteriālajiem līdzekļiem (ciprofloksacīnu, norfloksacīnu), daļa bija rezistenta arī pret piperacilīnu / tazobaktāmu, kotrimoksazolu un gentamicīnu.
Izvērtējot biofilmas producēšanu, novērots, ka viena (2 %) kultūra biofilmu neveido, 23 (51 %) kultūras biofilmu veido vāji, vidēja biofilmas veidošana tika novērota 12 (27 %) kultūrās, bet izteikta – 9 (20 %) kultūrās. Nozīmīga, t. i., vidēja vai izteikta, biofilmas produkcija novērota 21 (47 %) kultūrā (2. tab.). Trīs izmantotās references kultūras bija izteiktas biofilmas veidotājas. No astoņiem ESBL producējošajiem E. coli celmiem trīs biofilmu producēja vāji, četri – vidēji, bet viens – izteikti (3. tab.).
1. attēls. Bakteriofāgu lītiskā efekta vērtējums*, izmantojot divslāņu agara punktu metodi
Determination of bacteriophage lytic effect in double-layer agar spot method
* Dažāds bakteriofāgu lītiskais efekts: A un C platē fāgu lītisko efektu nenovēro, savukārt B platē ir atzīmēta bakteriofāgu pilna baktērijas lizēšana, D1 sektorā ir redzama atsevišķu negatīvo koloniju veidošanās, D2 sektorā – daļēja baktēriju līze.
Nosakot bakteriofāgu lītisko efektu, konstatēts, ka visu bakteriofāgu kopējais pozitīvais lītiskais efekts ir vērojams 38 (84 %) kultūrās (atsevišķu bakteriofāgu rezultātus sk. 4. tab.).
Izvērtējot bakteriofāgu lītisko efektu atkarībā no baktēriju spējas veidot biofilmu, konstatēts, ka celmos ar nozīmīgu biofilmas veidošanās pakāpi (vidēju un izteiktu) bakteriofāgu lītiskais efekts vērojams 18 (86 %) no 21 kultūras (sk. 2. tab.).
2. tabula. Bakteriofāgu lītiskais efekts atkarībā no baktērijas biofilmas veidošanās pakāpes
Evaluation of bacteriophage lytic effect among different biofilm production degrees of bacteria
| Biofilmas veidošanās pakāpe | Kultūru skaits, n | Pozitīvs bakteriofāgu lītiskais efekts, n |
|---|---|---|
| Nenovēro | 1 | 1 |
| Vāja | 23 | 19 |
| Vidēja | 12 | 12 |
| Izteikta | 9 | 6 |
Nedaudz atšķirīgi rezultāti iegūti, izvērtējot bakteriofāgu lītisko efektu ESBL producējošās E. coli kultūrās: pozitīvs bakteriofāgu efekts novērots 6 no 8 kultūrām, savukārt kultūrās ar nozīmīgu biofilmas veidošanos pozitīvs lītiskais efekts novērots 4 no 5 kultūrām (sk. 4. tab.).
3. tabula. Bakteriofāgu lītiskais efekts paplašināta spektra beta laktamāzes producējošās E. coli kultūrās atkarībā no baktērijas biofilmas veidošanās pakāpes
Evaluation of bacteriophage lytic effect among different biofilm production degrees of ESBL E. coli cultures
| Biofilmas veidošanās pakāpe | Kultūru skaits, n | Pozitīvs bakteriofāgu lītiskais efekts, n |
|---|---|---|
| Nenovēro | 0 | 0 |
| Vāja | 3 | 2 |
| Vidēja | 4 | 4 |
| Izteikta | 1 | 0 |
4. tabula. Bakteriofāgu lītiskā efekta izvērtējums (kultūru skaits, n)
Evaluation of bacteriophage lytic effect (cultures, n)
| Fāgs | Pilna baktēriju lizēšana | Daļēja baktēriju līze | Atsevišķu negatīvo koloniju veidošanās | Lītisko efektu nenovēro | Lītiskais spektrs, % |
|---|---|---|---|---|---|
| V1 | 1 | 8 | 2 | 34 | 24 |
| V10 | 6 | 24 | 3 | 12 | 73 |
| V12 | 0 | 11 | 3 | 31 | 31 |
| Piofag | 7 | 24 | 3 | 11 | 76 |
Diskusija
Pēdējo gadu laikā multirezistento mikroorganismu ierosināto infekciju skaits pieaug, savukārt efektīvu antibakteriālo līdzekļu skaits samazinās. Eiropas Komisija 2011. gadā ziņoja, ka ik gadu 25 tūkstoši cilvēku mirst bakteriālās rezistences dēļ. Eiropas Savienībā veselības sistēmas ekonomiskie zaudējumi multirezistences dēļ ir 1,5 miljardi eiro gadā, ESBL producējošas E. coli infekcijas gadījumā mirstības risks pieaug 3,57 reizes (European Commission, 2016; Melzer and Petersen, 2007).
Viena no biežākajām intrahospitālajām un sadzīvē iegūtajām infekcijām ir urīnceļu infekcija (aptuveni 30 % no nozokomiālajām infekcijām), bieži – ESBL producējoša (Lacovelli et al., 2014). Līdzīga tendence novērota arī mūsu veiktajā pētījumā, kur 18 % (n = 8) izolēto E. coli kultūru bija ESBL producējošas.
Aptuveni 85 % gadījumu urīnceļu infekcijas ierosinātājs ir E. coli, un to bieži saista ar baktērijas spēju veidot biofilmu jeb ekstracelulāru matrici, īpaši pacientiem ar urīnceļu katetru (Jacobsen et al., 2008). Biofilmas veidošana ir baktēriju aizsargmehānisms pret cilvēka imūnsistēmu, kā arī antibakteriālajiem līdzekļiem, kuri vāji penetrē biofilmu, padarot infekcijas perēkli grūti iznīcināmu.
Šajā pētījumā iegūtie rezultāti apstiprina, ka lielākā daļa (98 % jeb n = 44) izolēto E. coli kultūru spēj veidot biofilmu, tomēr atšķiras biofilmas veidošanas pakāpe, kas var būt izšķiroša efektīvas antimikrobiālās terapijas gadījumā. Liela uzmanība tiek pievērsta multirezistentām biofilmu producējošām baktērijām, jo šāda veida mikroorganismu iznīcināšana ir īpaši sarežģīta; visas izolētās ESBL producējošās E. coli kultūras spēja veidot biofilmu, bet nozīmīga, t. i., vidēja vai izteikta, biofilmas veidošana novērota 5 no 8 kultūrām.
Eiropas Savienībā ir izveidots rīcības plāns bakteriālās rezistences apkarošanā un ierobežošanā, kurš ietver jaunu antimikrobiālo līdzekļu izveidošanu un alternatīvu metožu attīstīšanu (European Commission, 2016; Centers for Disease Control and Prevention, 2013). Viena no šādām metodēm ir bakteriofāgu jeb baktēriju vīrusu izmantošana infekciju profilaksē un ārstēšanā (European Commission, 2015; Review on Antibacterial Resistance, 2016). Bakteriofāgiem piemīt spēja vairoties saimniekorganismā jeb baktērijā, un dzīves cikla beigās bakteriofāgs no tās izdalās, lizējot jeb iznīcinot to.
Izmantojot dažādus E. coli bakteriofāgus, šajā pētījumā konstatēts, ka kopējais bakteriofāgu lītiskais spektrs bija 84 % (n = 38). Bakteriofāgiem tiek novērots arī spēcīgs lītisks efekts baktēriju biofilmās, jo tie vairojas infekcijas perēklī un veido vielas, kuras spēj degradēt biofilmas struktūru (Abedon et al., 2015; Carson et al., 2010). Biofilmu producējošu baktēriju grupā (kopā 44 kultūrām) pozitīvs bakteriofāgu lītiskais efekts bija 37 (84 %) kultūrās.
Secinājumi
- No 45 izolētajām E. coli kultūrām 8 bija paplašināta spektra beta laktamāzes (extendedspectrum beta-lactamases – ESBL) producējošas, kas ir līdzīgi, kā konstatēts pētījumos citās Eiropas Savienības valstīs.
- In vitro biofilmu veidošanās tika novērota 44 (98 %) no 45 kultūrām, tomēr nozīmīga, t. i., vidēja vai izteikta, biofilmas veidošanās novērota 21 (47 %) kultūrā, kas liecina, ka klīniskajiem celmiem biofilmu veidošanās ir bieži sastopama.
- Bakteriofāgu lītiskais efekts bija atšķirīgs. Izmantojot dažādus bakteriofāgus, vislielākais lītiskais efekts novērots V10 bakteriofāgam (73 % jeb n = 33) un Piofag bakteriofāgu maisījumam (76 % jeb n = 34), savukārt V1 un V12 spektrs bija salīdzinoši šaurs (respektīvi, 24 % jeb n = 11 un 31 % jeb n = 14). (Sk. 4. tab.)
- E. coli celmos ar nozīmīgu biofilmas veidošanos bakteriofāgu lītiskais efekts novērots 18 no 21 kultūras jeb 86 %, kas ir salīdzinoši plašs un norāda, ka bakteriofāgiem piemīt lītisks efekts biofilmu producējošās kultūrās.
- No astoņām ESBL producējošām E. coli kultūrām piecas bija nozīmīgas biofilmas veidotājas. Šajā grupā pozitīvs bakteriofāgu efekts novērots četrām no piecām kultūrām, un tas liecina, ka bakteriofāgiem ir vērojams pozitīvs lītisks efekts ESBL producējošās E. coli kultūrās ar nozīmīgu biofilmas produkciju.
- Lai izvērtētu precīzu bakteriofāgu lītisko efektu biofilmās, ir jāveic tālāki pētījumi, izmantojot lielāku baktēriju kultūru skaitu un bakteriofāgu suspensiju modificētā 96 bedrīšu mikroplašu sistēmā, kur biofilmas tiek iepriekš izaudzētas un bakteriofāgu suspensija tiek izmantota biofilmas iznīcināšanā.
Abstract
Determination of Bacteriophage Lytic Effect among Uropathogenic Biofilm Producing E. coli Strains
In the past decades, multi-resistant bacterial infection rate has been increased. E. coli causes approximately 85 % of UTI (urinary tract infection), especially biofilm producing strains make the treatment more complex. Bacteriophages have a promising effect in bacterial biofilms, they are replicating at the site of infection and produce substances that degraded biofilm. There is little information about phage lytic activity in E. coli biofilms, especially in ESBL (extended-spectrum beta-lactamase).
The aim of the study was to evaluate bacteriophage lytic activity among biofilm producing uropathogenic E. coli strains.
45 E. coli strains were isolated from patients with UTI, three E. coli reference strains were used (ATCC – 33526, 35218, 25922). Biofilm production was detected by using 96 well microtiter plates. To determine biofilm production optical density, it was measured with ELISA reader. Biofilm production degree was calculated by each strain mean optical density compared with negative controls’ mean absorbance. Biofilm production was classified as “no”, “weak”, “moderate” or “strong” biofilm production. To evaluate bacteriophage lytic activity, spot test method was used. Bacteriophage lysate from “Piofag”, Mikrogen and three lytic E. coli bacteriophages were used. Phage effect was identified by plaque method.
Bacteriophage lytic activity among moderate and strong biofilm producer strains was 86 % (18 out of 21). There were 12 (27 %) moderate biofilm producers, 9 (20 %) strong, 23 (51 %) weak, 1 (2 %) no producer out of 45 E. coli strains. In ESBL E. coli strains (n = 8), four were moderate and one strong biofilm producer. Bacteriophage lytic activity among those strains was four out of five.
E. coli clinical isolates produce moderate and strong biofilms. Bacteriophages have a great lytic activity among biofilm producer strains as well as ESBL E. coli biofilm producer strains.
Literatūra
- Abedon, S. T. 2015. Ecology of anti-biofilm agents II: bacteriophage exploitation and biocontrol of biofilm bacteria. Pharmaceuticals. 8(3), 559–589. Iegūts no: doi:10.3390/ph8030559 (sk. 02.06.2017.).
- Carson, L., Gorman, P. S. and Gilmore, F. B. 2010. The use of lytic bacteriophages in the prevention and eradication of biofilms of Proteus mirabilis and Escherichia coli. Pathogens and Diseases. 59(3), 447–455. Iegūts no: doi:10.1111/j.1574-695X.2010.00696.x (sk. 17.05.2017.).
- Centers for Disease Control and Prevention. 2013. Antibiotic resistance threats in the United States. Iegūts no: http://www.cdc.gov/drugresistance/threat-report-2013/ (sk. 17.05.2017.).
- European Commission. 2015. Progress report on the Action plan against the rising threats from Antimicrobial Resistance. Iegūts no: http://ec.europa.eu/health/antimicrobial_resistance/docs/20… (sk. 17.05.2017.).
- European Commission. 2016. Antimicrobial resistance policy. Iegūts no: http://ec.europa.eu/dgs/health_food-safety/amr/index_en.htm (sk. 17.05.2017.).
- Hassan, A. et al. 2011. Evaluation of different detection methods of biofilm formation in the clinical isolates. 15(4), 305–311. Iegūts no: doi:10.1016/S1413-8670(11)70197-0 (sk. 07.06.2017.).
- Jacobsen, S. M., Stickler, D. J., Mobley, H. L. T. and Shirtliff, M. E. 2008. Complicated catheter-associated urinary tract infections due to Escherichia coli and Proteus mirabilis. Clinical Microbiology Reviews. 21(1), 26–59. Iegūts no: doi:10.1128/CMR.00019-07 (sk. 07.06.2017.).
- Lacovelli, V. et al. 2014. Nosocomial urinary tract infections: a review. Urologia Journal. 81(4): 191–252. Iegūts no: doi:10.5301/uro.5000092 (sk. 17.05.2017.).
- Melzer, M. and Petersen, I. 2007. Mortality following bacteraemic infection caused by extended spectrum betalactamase (ESBL) producing E. coli compared to non-ESBL producing E. coli. The Journal of Infection. 55(3): 254–259. Iegūts no: doi:10.1016/j.jinf.2007.04.007 (sk. 17.05.2017.).
- Reisner, A. et al. 2006. In vitro biofilm formation of commensal and pathogenic Escherichia coli strains: impact of environmental and genetic factors. Journal of Bacteriology. 188(10), 3572–3581. Iegūts no: doi:10.1128/JB.188.10.3572-3581.2006 (sk. 06.06.2017.).
- Review on Antibacterial Resistance. 2016. Tackling drug-resistant infections: final report and recommendations. Iegūts no: https://amr-review.org/sites/default/files/160518_Final%20p… (sk. 17.05.2017.).
- Rodrigues, L. B. et al. 2010. Quantification of biofilm production on polystyrene by Listeria, Escherichia coli and Staphylococcus aureus isolated from a poultry slaughterhouse. Brazilian Journal of Microbiology. 41(4), 1082–1085. Iegūts no: doi:10.1590/S1517-838220100004000029 (sk. 17.05.2017.).
- Stepanovic, S. et al. 2007. Quantification of biofilm in microtiter plates: overview of testing conditions and practical recommendations for assessment of biofilm production by staphylococci quantification of biofilms. APMIS. 115(8), 891–899. Iegūts no: doi:10.1111/j.1600-0463.2007.apm_630.x (sk. 17.05.2017.).